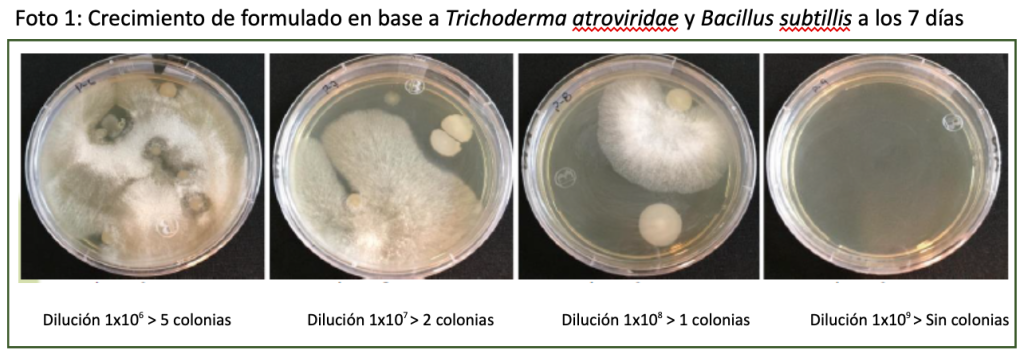

Agri Marine Terra (AMT), una empresa chilena fundada por profesionales del agro, vinculados especialmente a la agricultura orgánica, donde surgen desafíos productivos, tuvieron la iniciativa de comenzar a idear productos de alta calidad y eficiencia, que fuesen respetuosos con el medio ambiente y lograsen adecuarse tanto a los manejos orgánicos, como a la los convencionales e integrados. Desde el 2017 AMT está dedicada a la investigación, desarrollo y producción de insumos biológicos, teniendo hoy una amplia paleta de productos que van desde inoculantes foliares, de suelo y semillas, entre otros.

En una entrevista, Verónica Rodríguez, subgerente técnico de la empresa se refiere a la empresa propiamente tal, y también al desarrollo de formulaciones que van a entregar soluciones a los desafíos.
¿Cuáles son las mayores fortalezas de AMT como empresa y cuál es el sello de Agri Marine Terra?
Lo primero que se debe destacar en AMT es la rigurosidad de sus procesos; desde la recolección y selección de cepas, pasando por toda la cadena de producción, hasta el control de calidad previo a la salida al mercado; en este último punto es relevante destacar que cada lote pasa por un triple control de calidad, siendo el primero el de la fábrica, el segundo realizado por un laboratorio externo que es Ayslab, y un último control que lo hace nuestro partner distribuidor ADAMA, que como empresa internacional, es de rigor constatar que los estándares de calidad sean los adecuados, verificando que la concentración, es decir las UFC, sean las indicadas en la etiqueta, y que la pureza del formulado no presente ningún tipo de contaminación que pueda mermar la calidad del producto.
También es relevante la labor técnica que hacemos en terreno, pues apoyamos a los productores en la elaboración de sus programas a integrar adecuadamente el uso de los productos biológicos, de tal manera que puedan obtener y aprovechar el máximo potencial en cada aplicación. Apoyamos en la identificación y diagnóstico de las distintas problemáticas que pueda estar presentando el huerto, y a menudo hacemos seguimientos de los tratamientos recomendados, para ir verificando junto al productor los efectos y mejoras sobre su cultivo.
En esta etapa de la temporada, ¿cuáles son los productos de la línea biológica de AMT que están en mayor promoción para cerezos?
Biolife Psychro es el producto que mayor uso tiene desde caída de hojas hasta floración, ya que es un inoculante foliar formulado con dos cepas de Trichoderma atriviride y una cepa de Bacillus subtilis, que han sido seleccionadas por su resistencia a las bajas temperaturas invernales, son capaces de colonizar el tejido vegetal con temperaturas entre los 0 y 15°C; además este consorcio de microorganismos benéficos específicos (MOBE´s), presenta la más alta concentración dentro de los productos de la categoría en el mercado hoy en día; esto asegura un rápido asentamiento de los MOBE´s en las heridas generadas por la caída de hojas, en los cortes de poda y en las micro fracturas que se producen en algunas variedades sensibles en las heladas primaverales o a salida de invierno.
Debo mencionar también a Phyllobacter WP, que es un inoculante de la filósfera elaborado en base a estructuras de resistencia, endosporas, de dos cepas de Bacillus subtilis, que se encuentran a una altísima concentración, más de 1×1010 (10 mil millones) por gramo. Este formulado es muy versátil, ya que por la naturaleza de su composición, permite ser aplicado en conjunto con cobre u otros fungicidas, optimizando los tiempos de maquinaria en los campos y complementando las aplicaciones de los químicos.
Pensando en caída de hojas, que es el período que está comenzando, ¿cuál sería la recomendación de uso de Biolife Psychro?
Idealmente se recomienda una aplicación de Biolife Psychro al inicio de caída de hojas, con el fin de inocular toda las estructuras que ya están empezando su senescencia e invitan a la llegada de algunos microorganismos no deseados, entonces ayudamos a que la planta se pueda defender de mejor manera, y a su vez, en la medida que comienza la abscisión foliar, se irán colonizando con los microorganismos de Biolife Psychro, estas pequeñas heridas facilitando su cicatrización. Luego es recomendable repetir en un 50 a 75% de hojas caídas para restablecer las poblaciones de los microorganismos benéficos en lo que queda del proceso. Finalmente, se recomienda una tercera aplicación que se puede hacer coincidir con la poda que es uno de los usos más importantes de Biolife Psychro, dado a que los Trichodermas son capaces de colonizar rápidamente los cortes en la madera, estableciéndose como una barrera biológica mientras los Bacillus mediante la generación de biofilms facilitan y aceleran una adecuada y limpia cicatrización. La dosis estándar recomendada es de 250g/ha, con un mojamiento máximo de 1500L.
Si pudieras nombrar brevemente los 3 principales atributos de Biolife Psychro, ¿cuáles serían?
1°- La capacidad de los microorganismos de Biolife Pyschro de germinar, establecerse y crecer sobre el tejido vegetal a bajas temperaturas (0-15°C).
2°- Que Biolife Psychro es un consorcio de microorganismos con la concentración más alta del mercado, lo que asegura una rápida y efectiva colonización.
3°- La calidad del formulado es irrefutable, tanto en su pureza como en la efectividad de sus cepas, ya que cada lote pasa por un triple control de calidad, cada uno hecho por laboratorios certificados.
A partir de tres repeticiones por dilución, se observó un promedio de 1 colonia de hongos en 100 μL de la dilución 1 x 10-8. Esto equivale a un recuento de 1 x 109 UFC/g.